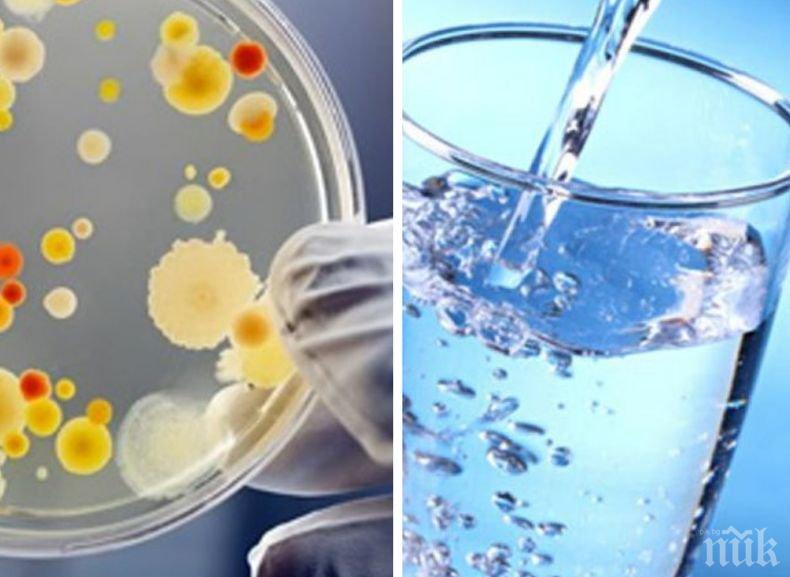
ВАЖНО: Спират водата в части от Бояна

ПИК с нов канал в Телеграм
Последвайте ни в Google News Showcase
"Софийска вода" временно ще прекъсне водоснабдяването в част от кв. "Бояна" днес, съобщиха от дружеството.
Във връзка с реконструкцията на водопровод на ул. "Шишманова конница" в кв. "Бояна" се налага спиране на водоподаването от 9.00 до 21.00 ч. на живеещите в района на ул. "Брезите" - от ул. "Матей Преображенски" до ул. "Шишманова конница", и на ул. "Шишманова конница" - от ул. "Кикиш" до ул. "Асен Георгиев".
Ремонтните дейности ще осигурят по-добро управление на водопроводната мрежа като максимално се ограничат зоните на евентуални бъдещи нарушения на водоснабдяването.
Засегнатите от прекъсването на водата, могат да получат повече информация от Телефонния център на “Софийска вода” АД на телефон 0800 12121 или да следят за развитието на всички текущи теренни дейности в реално време чрез Виртуалния информационен център на дружеството - http://www.sofiyskavoda.bg/water_stops.aspx .
“Софийска вода” АД предварително се извинява на своите клиенти за причинените временни неудобства!
Интернет сайтът на дружеството (www.sofiyskavoda.bg) дава възможност на клиентите да се абонират за съобщенията за прекъсване на водоподаването. На електронната си поща те могат лично да получават информация за планираните спирания. Друг начин е да се възползват от безплатната услуга за известяване чрез СМС.